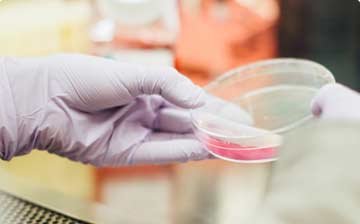
wrappixel kit

We are Leading Health Care Hospital in NewYork
You can relay on our amazing features list and also our customer services will be great experience.
Online Appointment
You can relay on our amazing features list and also our customer services will be great experience.
Latest Technologies
You can relay on our amazing features list and also our customer services will be great experience.
Experienced Team
You can relay on our amazing features list and also our customer services will be great experience.
Powerful Services at Medika
You can relay on our amazing features list and also our customer services will be great experience for you without doubt and in no-time
Dental Care with Easy Treatments
You can relay on our amazing features list and also our customer services will be great experience.
Lets TalkWe are Heart Specialist and Surgeon
You can relay on our amazing features list and also our customer services will be great experience.
Lets TalkWe do have Department for Research
You can relay on our amazing features list and also our customer services will be great experience.
Lets TalkChild Care Department for Everyone
You can relay on our amazing features list and also our customer services will be great experience.
Lets TalkExperienced Team of Doctors
You can relay on our amazing features list and also our customer services will be great experience for you without doubt and in no-time
Heart Sergeon
You can relay on our amazing features list and also our customer services will be great.
Learn More
Family Physician
You can relay on our amazing features list and also our customer services will be great.
Learn More
Cancer Care Specialist
You can relay on our amazing features list and also our customer services will be great.
Learn More
General Care
You can relay on our amazing features list and also our customer services will be great.
Learn MoreLess Invasive. Best Outcomes.
You can relay on our amazing features list and also our customer services will be great experience for you without doubt and in no-time
Lorem ipsum dolor sit amet, consectetuer adipiscing elit, sed diam nonummy nibh euismod tincidunt ut laoreet dolore magna aliquam erat volutpat.
Learn more
Lorem ipsum dolor sit amet, consectetuer adipiscing elit, sed diam nonummy nibh euismod tincidunt ut laoreet dolore magna aliquam erat volutpat.
Learn more
Lorem ipsum dolor sit amet, consectetuer adipiscing elit, sed diam nonummy nibh euismod tincidunt ut laoreet dolore magna aliquam erat volutpat.
Learn more
Lorem ipsum dolor sit amet, consectetuer adipiscing elit, sed diam nonummy nibh euismod tincidunt ut laoreet dolore magna aliquam erat volutpat.
Learn moreCustomer Reviews
Lorem ipsum dolor sit amet, consectetur adipisicing elit, sed do eiusmod tempor incididunt ut labore et dolore magna aliqua. Ut enim ad minim veniam, quis nostrud exercitation ullamco laboris nisi ut aliquip ex ea commodo consequat.
Simon Duo
Partner, Brevin
Customer Reviews
Customer Reviews
Lorem ipsum dolor sit amet, consectetur adipisicing elit, sed do eiusmod tempor incididunt ut labore et dolore magna aliqua. Ut enim ad minim veniam, quis nostrud exercitation ullamco laboris nisi ut aliquip ex ea commodo consequat.
Simon Duo
Partner, Brevin
Customer Reviews
Customer Reviews
Lorem ipsum dolor sit amet, consectetur adipisicing elit, sed do eiusmod tempor incididunt ut labore et dolore magna aliqua. Ut enim ad minim veniam, quis nostrud exercitation ullamco laboris nisi ut aliquip ex ea commodo consequat.
Simon Duo
Partner, Brevin
Customer Reviews